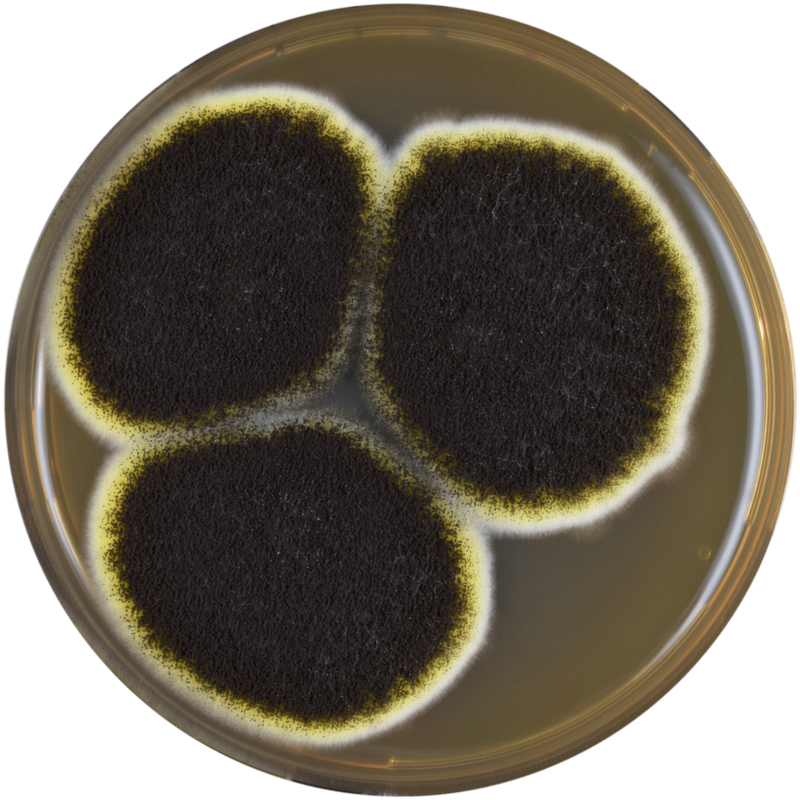

Американские ученые из Пенсильванского университета выяснили, каким образом грибки создают мощные лекарственные соединения. Исследование опубликовано в научном журнале Американского химического сообщества (JASC).
Хотя производимый плесенью антибиотик пенициллин был открыт почти 100 лет назад, процесс синтеза лечебных веществ внутри грибковых культур долгое время оставался непрозрачным. Это особенно касалось циклопентахромона — ключевого строительного белка, чьи производные эффективны против воспаления и помогают в борьбе с раком.
Химики добились прогресса в создании производных хромона в лабораторных условиях, однако отличительную структуру молекулы оказалось трудно точно и надежно скопировать.
В новом исследовании ученые нашли неизвестное промежуточное соединение под названием 2S-ремиспорин A, которое вырабатывается недавно открытым ферментом IscL.
Специалисты расшифровали структуру этих элементов и выяснили, что 2S-ремиспорин A способен катализировать создание различных соединений с циклопентахромоном. Эта возможность обусловлена наличием атома серы, который связывается с атомами углерода подобно сцепному устройству грузовика.
Исследователи рассчитывают, что открытие поможет дальнейшему продвижению использования грибковых соединений в медицине.
Ранее ученые нашли необычные грибковые структуры в носах людей с аллергическим насморком.